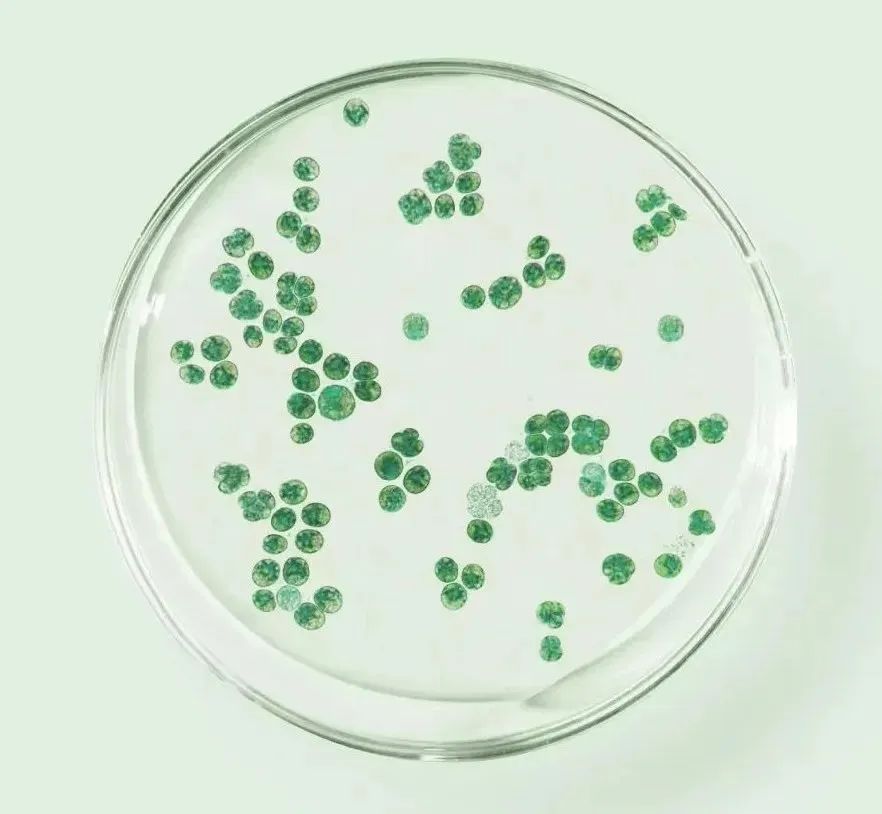

低GI食品助力控糖

慢性疾病◎糖尿病
世界卫生组织在2023年发布的一份卫生统计报告中的数据显示,2022年,全球约有5.63亿人患有糖尿病。这个数字比前一年增加了1.63亿人,其中大多数生活在低收入和中等收入国家。
2022年,中国约有1.44亿人患有糖尿病。与前一年相比,增加了4400万人,占全球糖尿病患者的近四分之一。2022年,中国有近110万人死于糖尿病,占全球糖尿病死亡人数的近三分之一。

糖尿病☆诊断标准
根据2023版的标准,糖尿病的诊断主要包括以下三个方面:
1.空腹血糖:空腹血糖≥7.0mmol/L(126mg/dL)表示患者正在处于糖尿病状态;
2.口服葡萄糖耐量试验(OGTT):2小时血糖≥11.1 mmol/L(200mg/dL);
3.糖化血红蛋白(HbA1c):HbA1c≥6.5%(48mmol/mol)。
此外,标准还提出了另外两个糖尿病风险的诊断:
1.略高于正常水平的空腹血糖(IFG):空腹血糖为6.1至6.9mmol/L(110至125mg/dL)。虽然这并不足以诊断糖尿病,但是它代表患者的胰岛素敏感度已经发生了一定的变化,已经出现了糖尿病的先兆。
2.稳定的葡萄糖异常转移(SITA):又称为糖尿病前期,是指血糖水平在IFG和OGTT标准之间,即在口服葡萄糖耐量试验期间2小时血糖为7.8至11.0mmol/L(140至199mg/dL)。这表明患者存在风险,可能会发展成糖尿病。

低GI★维持血糖水平
随着我国糖尿病、心血管疾病、肥胖等慢病人群的逐年增加,低GI食品的需求也在不断增大,同时,科技赋能促使低GI食品产业蓬勃发展,主食类的低GI食品也在不断涌现。
GI值是指血糖生成指数,又称“升糖指数”。反映了餐后2小时内食物对血糖浓度的波动影响。食物GI值越大,升糖速度越快。GI值≤55的食物为低GI食物。低GI食物是指食用这种食物使血糖升高的速度比较慢,血糖的峰值比较低。这样的食物对血糖影响较小,有利于餐后血糖稳定。所以,糖前期和糖尿病患者应尽量选择低GI值食物。那么如何分辨低GI食物呢?
我们一般将GI值≤55的食物称为低GI食物,55<GI<70称为中GI食物,GI≥70称为高GI食物。
另外,并不是同一种类的食物GI值都是相同的、一成不变的,不同品种、烹调方式、食物中其他成分的含量变化等都会影响GI值,影响血糖波动,例如:
糯性食材GI值高,如糯玉米、糯米粉、汤圆,粽子
加工越精细,升糖越快,如果汁>水果,杂粮粥>杂粮饭
食品经晒干、膨化、糊化等方式加工后,GI值升高,比如果干、膨化食品

难以辨认低GI食品?认准GGU认证
根据国家有关规定,只有通过低GI食品认证的产品,才可以在包装、标签、广告、宣传、说明书等使用“低GI食品认证标志”。
由于目前市面上的商品种类繁多复杂,作为普通消费者,我们很难准确辨别出哪些是低GI食品。这时,我们可以选择带有由全球绿色联盟(北京)食品安全认证中心(简称GGU)认证的“低GI食品认证”标志的产品。
全球绿色联盟(北京)食品安全认证中心是国家市场监督管理总局批准的第三方独立认证机构,也是国内领先的专注于食品领域创新型认证的专业机构。对外简称“GGU”或“GGU认证”。通过专业、权威的认证,为消费者提供品质保障和选购便利。
GGU也是国内首家推出低GI食品认证的专业认证机构。通过严格、专业的认证制度和流程,GGU为辽宁启康生物科技有限公司的天酶莱茵衣藻营养冲调粉颁发了《低GI食品认证证书》和《富硒食品认证证书》。获准在通过认证的产品外包装上使用低GI食品认证标志和富硒食品认证标志。该认证证书在国家市场监督管理总局全国认证认可信息服务平台及全球绿色联盟(北京)食品安全认证中心官网均可查,具有法律效力,全国通行。



莱茵衣藻助力控糖
莱茵衣藻(Chlamydomonas reinhardtii )是单细胞真核光合藻类,是人类可食用的天然藻类,来源稳定、安全。莱茵衣藻含有丰富的营养元素,包括高含量的优质蛋白质、粗多糖、膳食纤维、不饱和脂肪酸、矿物质等,其中蛋白质≥30.0%、粗多糖≥10.0%,在医学、酶制剂、食品等方面都有广泛应用。采用非转基因育种技术,以全球领先的生物发酵方式进行封闭快速繁殖,无化肥,无农药,无过敏原。
利用莱茵衣藻的特性,启康生物科技打造出莱茵衣藻营养冲调粉。其中,莱茵衣藻添加量30%,血糖生成指数低于日常精粮主食,不仅营养丰富,食用方便,还满足了糖尿病、高血糖、高血脂等血糖敏感人群的健康饮食需求。同时,丰富的膳食纤维可以促进胃肠道蠕动,有效维持肠道健康。

定时定量,两增三忌,坚持饮食调理
定时定量——进食要定时定量,使血糖保持平稳,糖尿病患者合理饮食的同时,要和药物相配合,不可过度节食,预防低血糖。
两增三忌——保证每日膳食纤维摄入25-30g,增加富含维生素和钙等食物,如蔬菜、低糖水果、豆制品等。忌烟酒;忌糖果、点心、甜饮料;忌煎炸烧烤类。
除此之外,建议调整吃饭顺序,按照一口蔬菜、一口肉、一口米饭的顺序饮食,平衡高GI主食所引起的血糖波动。
最后要树立信心,坚持合理饮食,不可轻易放弃。






